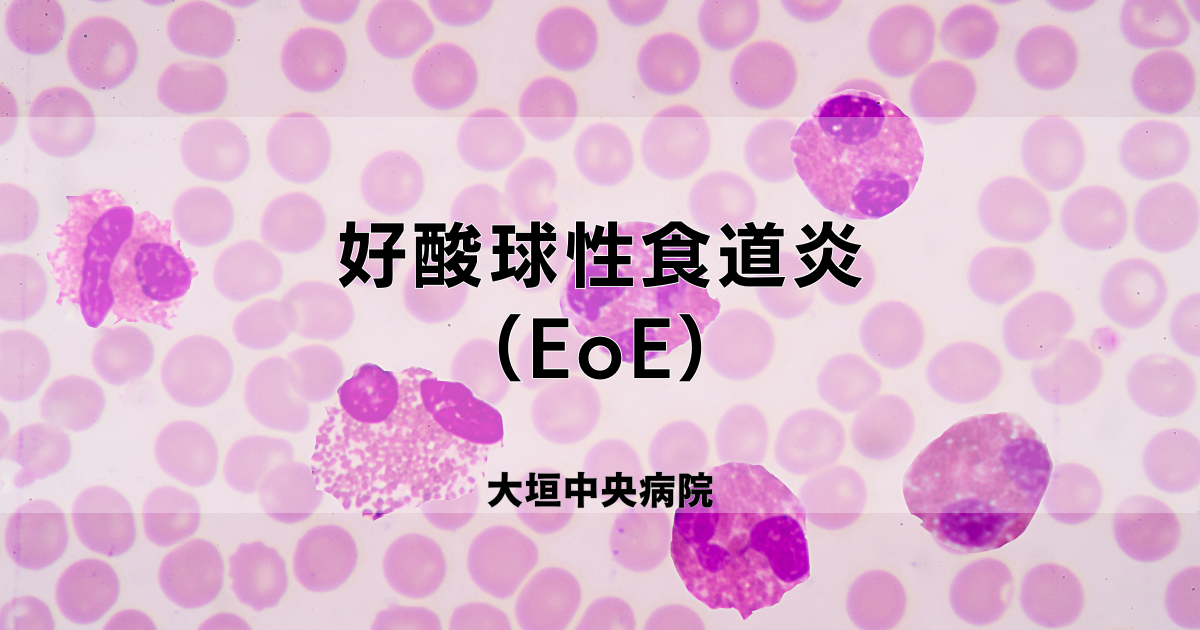
EoE に Dupixent を使用する必要がある期間

デュピクセントは、成人および特定の小児の好酸球性食道炎の治療に使用できます。この記事では、デュピクセントを使用する期間、薬の仕組み、副作用などのトピックについて説明します。
重要なポイント
- デュピクセントは、好酸球性食道炎(EoE)の治療に使用されるブランドの注射薬で、通常は週に 1 回 300 ミリグラムの用量で処方されます。主に成人に使用されますが、場合によっては子供にも処方されることがあります。ジェネリック型はデュピルマブと呼ばれます。
- デュピクセントは、腫れの原因となる特定のタンパク質をブロックすることで機能します。これにより、喉の腫れが軽減され、嚥下困難や胸痛などの症状が緩和され、EoEが治療されます。
- デュピクセントは、注射部位の反応、関節痛、副鼻腔炎などの副作用を引き起こす可能性があります。これらは通常は軽度で自然に治りますが、数週間続く場合は医師に相談することを検討してください。
好酸球性食道炎 (EoE) は、食道の炎症を引き起こす長期的な症状です。 (食道は口と胃をつなぐ管です。) EoE の症状には、嚥下困難、胸痛と胃痛、吐き気と嘔吐、胸やけ、食欲不振などがあります。
EoE の治療には通常、食事の変更と薬物療法の組み合わせが含まれます。デュピクセントは、この状態の症状を管理するために使用できる薬の 1 つです。
デュピクセントを使用できる期間、薬の仕組み、薬の副作用について詳しく知りたい方は、以下をお読みください。
EoE は長期にわたる症状であり、デュピクセントは長期治療を目的としています。あなたと医師がデュピクセントが安全で効果的であると判断している限り、おそらく長期間使用することになるでしょう。
推奨用量
デュピクセントは、体重 15 キログラム (kg) 以上の成人および 1 歳以上の小児の EoE を治療するために食品医薬品局 (FDA) によって承認されています。 1 kg は約 2.2 ポンド (ポンド) に相当します。 (たとえば、15 kg は約 33 ポンドです。) デュピクセントは皮下注射として投与されます。
成人の場合、Dupixent の推奨用量は 300 mg を週 1 回投与します。
小児の場合、デュピクセントの推奨用量は体重によって異なります。
- 体重 15 kg ~ 30 kg 未満の子供の場合、Dupixent の推奨用量は 200 mg を隔週で投与します。
- 体重が 30 kg から 40 kg 未満の子供の場合、Dupixent の推奨用量は 300 mg を隔週で投与します。
- 体重が40kg以上の子供の場合は、大人と同じ量が推奨量となります。
デュピクセントの推奨用量について質問がある場合は、あなたまたはあなたのお子様の医師にご相談ください。
デュピクセントは、体内で炎症を引き起こす可能性のある 2 つのインターロイキン (タンパク質) をブロックします。これらのタンパク質をブロックすることで、デュピクセントは食道の炎症を軽減し、腫れを軽減します。これにより、EoE の症状がより管理しやすくなります。
Dupixent が機能し始めるまでにかかる時間
デュピクセントは最初の注射後に効果を発揮し始めます。ただし、症状の改善に気づくまでに数週間かかる場合があります。
16週間の治療後も症状が改善しない場合は、医師に相談してください。デュピクセントの服用を続けるべきか、それとも別の治療法に切り替えるべきかについて相談できます。
EoE に Dupixent を使用すると、軽度または重度の副作用が発生する可能性があります。 Dupixent を EoE に使用した場合のより一般的な副作用は次のとおりです。
- 腫れ、痛み、あざなどの注射部位の反応
- 副鼻腔炎を含む上気道感染症
- 関節痛
- 既存の口唇ヘルペスの再燃、口唇ヘルペスの原因、または他の既存のヘルペス感染症の再燃
デュピクセントのこれらの副作用は一時的なもので、数日から数週間続く場合があります。ただし、症状がこれより長く続く場合、または気になる場合や重症になる場合は、医師または薬剤師に相談することが重要です。
デュピクセントの使用中に重篤な副作用が発生した場合は、すぐに医師に連絡してください。副作用が生命を脅かすと思われる場合、または医療上の緊急事態が発生していると思われる場合は、すぐに 911 または最寄りの緊急電話番号に電話してください。
注:デュピクセントは他の症状の治療にも承認されています。デュピクセントの副作用は、治療に使用されている症状によって異なる可能性があることに注意することが重要です。
EoE は食道に炎症を引き起こし、嚥下困難や胸やけなどの症状を引き起こす可能性があります。デュピクセントは、EoE の治療とそれらの症状の管理に使用できる処方薬です。それはあなたにとって安全で効果的である限り、長期的な治療となることを目的としています。
デュピクセントは、炎症を引き起こす可能性のある体内の 2 つのタンパク質をブロックすることによって機能します。これにより、食道の腫れが軽減され、EoE の症状が管理しやすくなります。
他の薬と同様に、デュピクセントは副作用を引き起こす可能性があります。 EoE に使用される場合、より一般的な副作用には、注射部位の反応や関節痛などがあります。
EoE での Dupixent の使用について詳しくは、医師または薬剤師に相談してください。
好酸球性食道炎 (EoE) に対するデュピクセントの使用・関連動画
参考文献一覧
- https://www.accessdata.fda.gov/drugsatfda_docs/label/2024/761055s059lbl.pdf